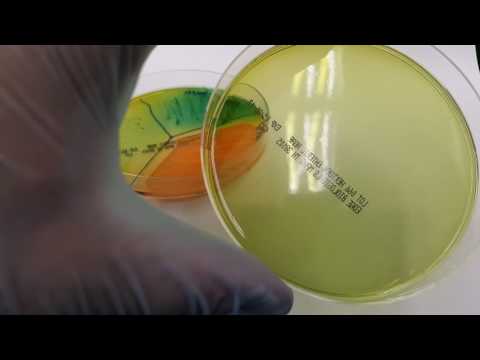
download lagu mp3 mp4 Hektoen, download lagu Hektoen gratis, unduh video klip Hektoen

Hektoen }}- The difference between Salmonella sp., Shigella sp., and rapid fermenters.
Before downloading Hektoen Videos , Download and listen MP3 songs free online. Watch new Bollywood songs and latest popular Hindi songs, English and regional movies, TV shows and videos online
Hektoen Free Download Audio Mp3 and Mp4 :
Music Discovery, Charts and Song Lyrics : Microbiology: Hektoen Enteric Agar | Hektoen
Microbiology: Hektoen Enteric agar - Hektoen - The difference between Salmonella sp., Shigella sp., and rapid fermenters.
Music Discovery, Charts and Song Lyrics : Can You Guess These Colonies On Hektoen Enteric Agar ??? ( Micro Q&A - 11 ) | Hektoen
Can you guess these colonies on Hektoen Enteric Agar ??? ( Micro Q&A - 11 ) - Hektoen - Hello Viewers !!! My Name Is Kavindu Lakmal , Medical Laboratory Science Student From University Of Peradeniya. I hope this video will helpful for your studies ...
Music Discovery, Charts and Song Lyrics : Selective And Selective/Differential Media Time-lapse | Hektoen
Selective and Selective/Differential Media Time-lapse - Hektoen - Time-lapse clips of selective and selective/differential media. Includes 6.5 % Salt, M-staph, M.S.A, Bile Esculin, EMB, MacConkey and Hektoen Enteric Agar.
Music Discovery, Charts and Song Lyrics : How To Isolate Bacteria On Hektoen Agar Part 3 | Hektoen
How to isolate bacteria on Hektoen agar Part 3 - Hektoen - DANGEROUS EXPERIMENT WITH Potentially pathogenic bacteria! DO not try this at Home!
Music Discovery, Charts and Song Lyrics : Salmonella Shigella (SS) Agar. | Hektoen
Salmonella shigella (SS) Agar. - Hektoen - Hi my dear viewers, I am undergraduate medical laboratory science (BSc. SP) student in university of Peradeniya in Srilanka. According to one of my friend's ...
Identify the media playing around you Hektoen explore the music you love [ Discover song lyrics from your favourite artists Salmonella shigella (SS) Agar., Hektoen &] Music Mp3 and Mp4 download that gives you an access to thousand of songs. Download free music, free Mp3, Free Mp4, top charts, playlists, new releases and offline listening.
Post a Comment
Post a Comment